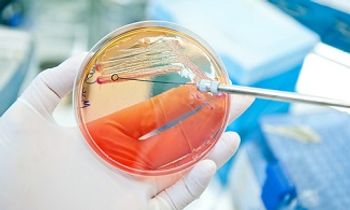

Prevention
Latest News

Cytomegalovirus Vaccine Candidate Found to Be Safe & Immunogenic in First-in-Humans Trial
Latest Videos

CME Content
More News

A new report on influenza vaccination rates among US health care workers finds that employer requirements help keep vaccination rates of health care workers higher than that of the general public.

Efforts such as improved indication documentation and antimicrobial stewardship involvement may improve patient outcomes in some patients who are on outpatient parenteral antimicrobial therapy (OPAT) for ease of administration (EOA) that are readmitted to the hospital.

New software to facilitate prior authorization helped streamline the approval process and increase antimicrobial use tracking at the Hospital of the University of Pennsylvania.

Study results indicate that clinicians start prescribing new drugs off-label almost as soon as the drugs become available.

The new vaccine schedule is 7 days between doses for adults aged 18 to 65, instead of the standard 28 days.

Researcher give insight into the importance of antibiograms in outpatient management of urinary tract infections

Mary Choi, MD, MPH, discusses the progress made in treating and preventing Ebola and the challenges of fighting the community resistance of the Congolese.

A look into the challenges of including infection preventionists in antimicrobial stewardship programs.

Despite current recommendations, Tdap vaccine coverage in pregnant women remains suboptimal.

Mindy Smith, BSPharm, RPh, provides tips for recommending the flu shot to patients who are more likely to get the flu.

In case you missed them, we've compiled the top five infectious disease articles from this past week.

New surveillance report sheds light on meningococcal disease rates among HIV-infected MSM.

Dale N Gerding, MD, provides insight about prevention options for C diff that are expected in the future.

In allogenic hematopoietic cell transplant patients, auto-FMT treatment led to the recovery of beneficial gut bacteria close to baseline levels within days.

Plenty of research has gone into the causes and progression of Alzheimer’s disease. Now a new effort aims to make the case that scientists have been looking in the wrong direction.

Colleen Kelley, MD, discusses the possibility of an HIV vaccine and current progress being made in HIV prevention.

Hepatitis A outbreaks are active in 13 states across the United States, yet vaccination is required in only a fraction of them.

The FDA has granted QIDP and fast track designations to Cidara Therapeutics’ prophylaxis development program for rezafungin, their lead antifungal product candidate.

Global health officials are concerned about the potential consequences of the disruption to Ebola surveillance in the DRC outbreak caused by civil unrest.

By itself, the POET trial should not fundamentally change the current approach to infective endocarditis treatment.

An examination of 17 years of data reveals that children who received the combination acellular vaccine Tdap were vulnerable to pertussis much earlier than expected. Researchers are hopeful that new vaccines will extend protection against the disease.

The NIAID is sponsoring a phase 1 clinical trial to assess if a nasal influenza vaccine candidate used in combination with a licensed vaccine can enhance immune responses against influenza in children and teens.

Investigators find that severe hospitalization cases of varicella still occur in vaccinated children, yet not vaccinating against the virus confers the greatest threat.
The program calls for new research and development incentives, veterinary stewardship, and enhanced surveillance.

Mindy Smith, BSPharm, RPh, shares common misconceptions about the flu shot and how providers can advocate for the vaccination to their patients.









































































































































